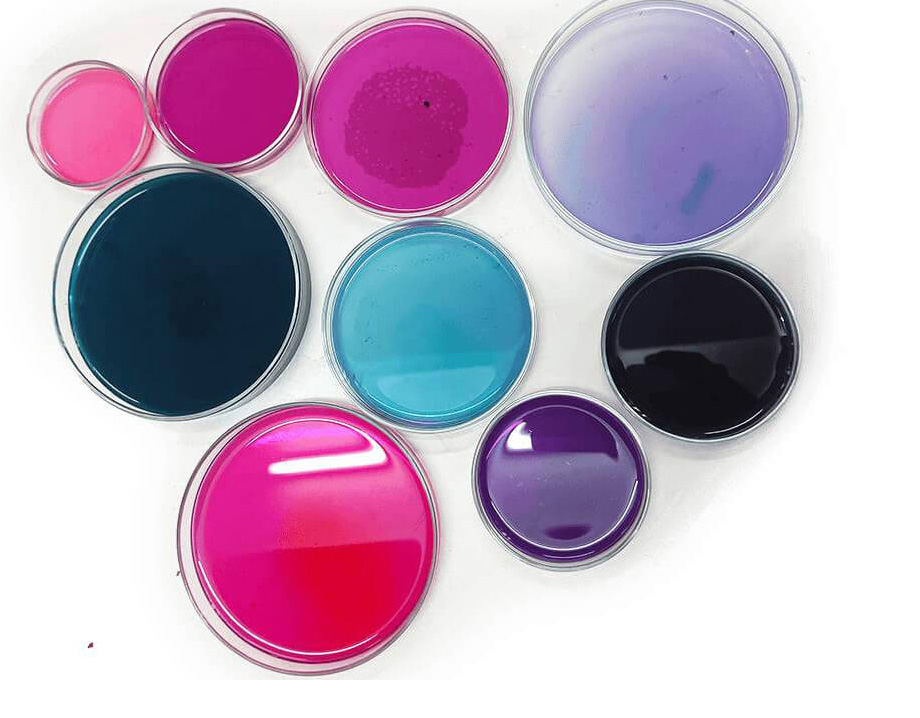
Textiles and Surfaces
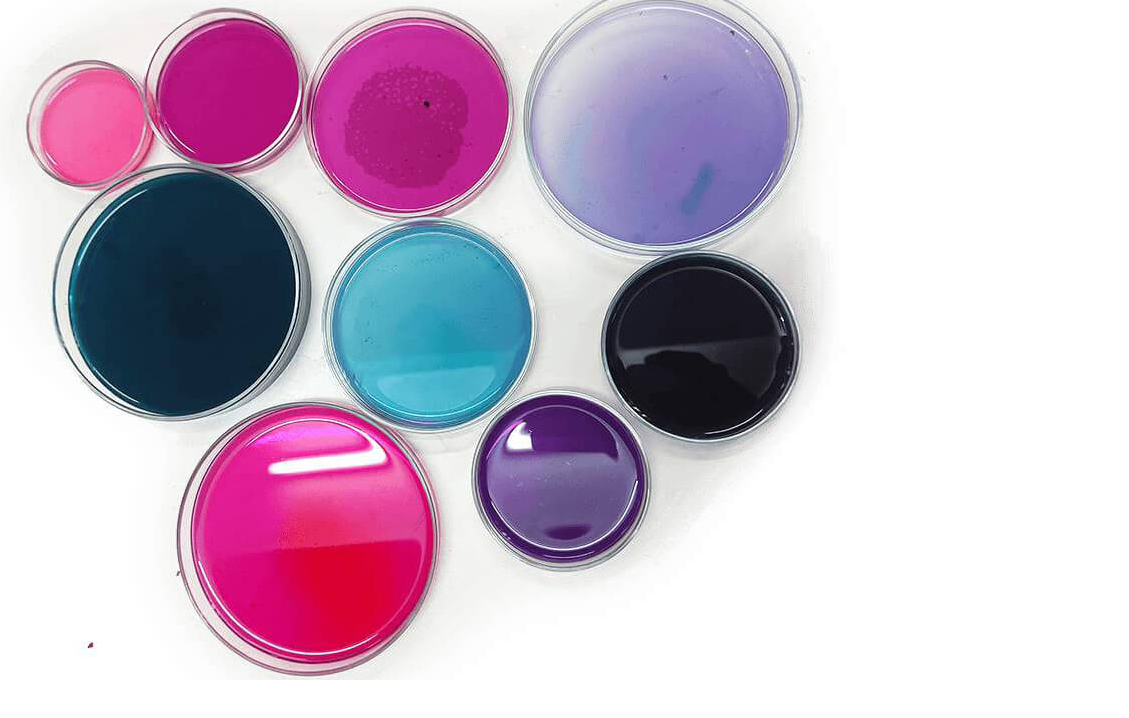
Unflatables

I EXPLORE THE INTERSECTION OF DIGITAL FABRICATION, INTERACTION DESIGN, AND MATERIALITY THROUGH EXPERIMENTAL MAKING

Soft Robotics
I research soft robotics, pneumatic actuators, and haptic feedback systems that bridge the physical and digital worlds. My projects explore how soft, flexible materials can create intimate, responsive interactions between humans and technology.

Digital Fabrication
I combine traditional craftsmanship with digital tools through projects ranging from custom electronics design to CNC machining. My work explores how digital fabrication can enhance material properties and create new possibilities for design.
Textiles and Surfaces
I explore textile manipulation, natural dye processes, and sustainable surface treatments. My work focuses on environmentally conscious approaches to textile design while investigating innovative techniques for creating dynamic, responsive materials.

Bio/material research
I investigate bio-based materials and sustainable fabrication processes. My research explores alternatives to synthetic materials through experimentation with bacteria, fungi, and other biological systems an biopolymers, developing new approaches to environmentally conscious design.

Visual Communication
My visual communication work spans brand identity, data visualization, and experimental graphics. Trained at the Academy of Fine Arts in Katowice, I focus on contemporary design approaches that bridge traditional craftsmanship with digital innovation and visual storytelling.